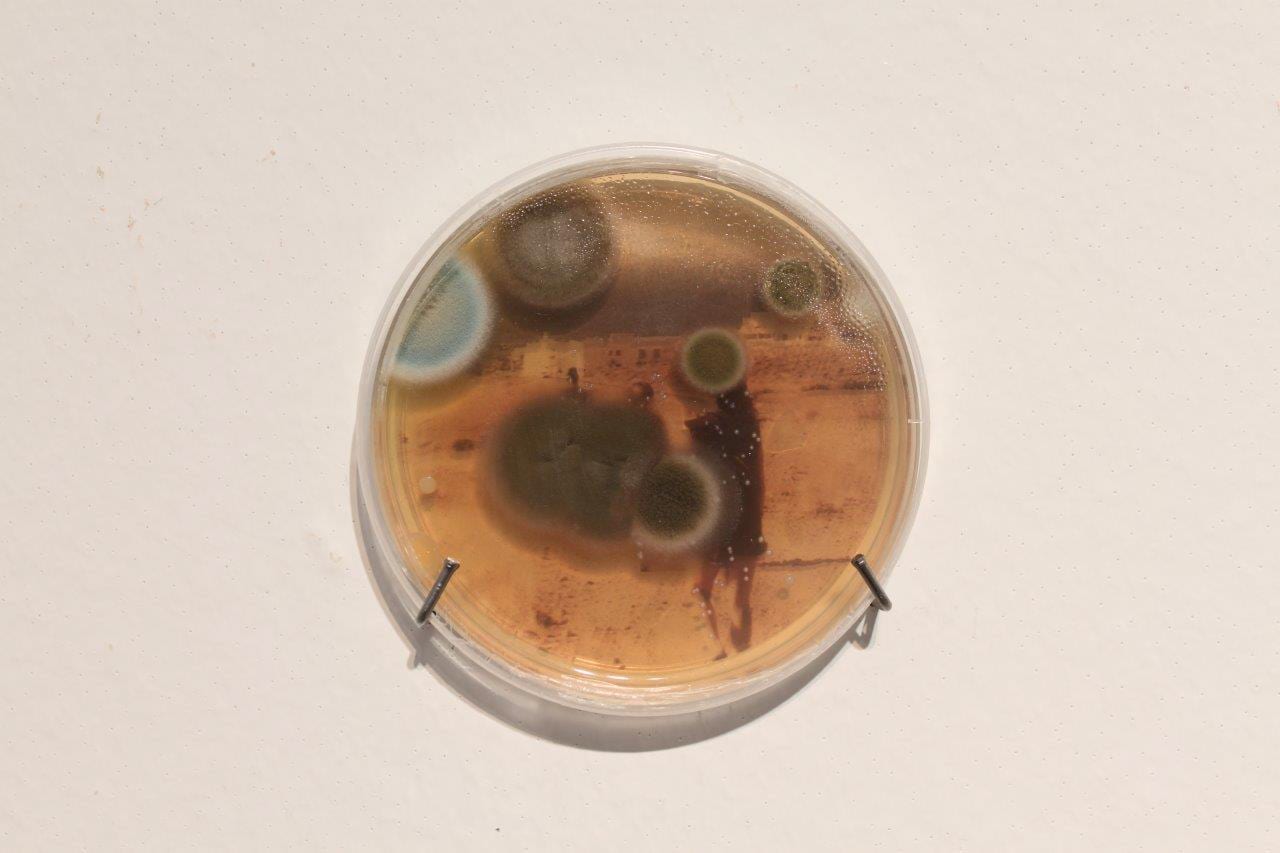

Location: Granada, Spain
I. INTRODUCTION

IONI, Paz Tornero, 2018.
I AM VERY INTERESTED IN integrating the innovation, creativity and critical thinking of artists into broader social perspectives that challenge a ‘formalized’ dependence on social patterns dominated by technology, science and political power. Below I share my images and reflections on my 2018 project Ioni, a video of my transdisciplinary approach, and an interview on my work published by CLOT Magazine.
MY PROJECTS ARE GUIDED by wide-ranging questions on the relationships between the sovereignty of nature, technology and science. These include: who holds environmental and technoscientific control; what are the links between policy research in sustainable and scientific development and the hegemony of the market and politics; what complex interdependencies exist between society, nature and networked media, interpersonal relational behaviors, and identity in a (bio)technological world; and how do these media modify the structure and nature of our collective (as societies) and individual (as people) entities.
II. IONI, 2018

IONI, Paz Tornero, 2018.
I CREATED IONI in 2018 for the group exhibition Narrativas en las Fisuras del Espacio y el Tiempo (Narratives in Time and Space´s Fissures), at the Museum of the University of Alicante (MUA).

IONI, Paz Tornero, 2018.
This piece is a reflection on identity, and the ephemeral and temporal character of family trace. I developed it over a week in a microbiology laboratory. It is composed of several Petri dishes that contain photographs of the my personal life, plus my own vaginal bacteria on the nutrient medium that feeds it.
Following the safety protocols in the laboratory to avoid any kind of environmental contamination, mushroom proliferation being very frequent, some plates have rapidly developed fungal spores that will continue to grow until the images are “erased.”

IONI, Paz Tornero, 2018.

IONI, Paz Tornero, 2018.

IONI, Paz Tornero, 2018.
I wanted to use vaginal bacteria that represent, in the case of a cis female body, the identity or ID, because of its close relationship with the gut microbiota. According to recent studies, vaginal flora is formed in the intestine and we already know that the gut microbiota is unique in every human being. It is our inner fingerprint. In different traditions the vagina symbolizes space, emptiness, source and vacuity.
IONI, Paz Tornero, 2018.

IONI, Paz Tornero, 2018.
The installation included the petri dishes, and a video with images of my augmented body.

IONI, Paz Tornero, 2018.

IONI, Paz Tornero, 2018.

IONI, Paz Tornero, 2018.
Below are screen shots from the video of my augmented body. This work reflects the ephemeral nature of the traces of our body, which changes and disappears over time:

IONI (video still), Paz Tornero, 2018.

IONI (video still), Paz Tornero, 2018.

IONI (video still), Paz Tornero, 2018.

IONI (video still), Paz Tornero, 2018.

IONI (video still), Paz Tornero, 2018.

IONI (video still), Paz Tornero, 2018.
III. TRANSDISCIPLINARY ART/SCIENCE METHODS
AS AN ARTIST, I COLLABORATE with science laboratories and work with scientific methods, combining art, the sciences and environmental work. In the video below, which I shared on the “Training Methods for Transdisciplinary Collaboration” panel of the 2017 ISEA Festival on Biocreation & Peace held in Manizales, Colombia, I explain my work with the Microbiology Institute of the San Francisco de Quito University in Quito, Ecuador. I was a member of the faculty, a researcher, and a visiting artist in the Microbiology Institute. I created the Transdisciplinary Research Lab, where I worked with students on projects with the Department of Environmental Communication, Environmental Protection and Sustainability Initiative. I share my experiences and conclusions, and subsequent work outside the academy through FactorÃa Cultural.
IV. INTERVIEW BY ŽIVA BRGLEZ, CLOT MAGAZINE
ŽIVA BRGLEZ: You are a professor and researcher at the School of Fine Arts at the University of Granada (Spain), for those that are not familiar with your work, could you tell us a bit about your background and how and when your interest on the crossover of science and art come up?
PAZ TORNERO: My great interest in the scientific field and its relationship with the arts stems from my academic background in high school, where I studied a specialization in the sciences, while having a professional career in dance. In my spare time I liked drawing. After that I went to Granada to study physics at the university, but a year later decided to leave it and study art at the Polytechnic University of Valencia.
During those years, my studies were focused not only on drawing and sculpture techniques, but also on the use of audiovisual practices, installations, sound art and digital tools. With these specializations I was able to obtain several scholarships that allowed me to visit other institutions abroad and expand my curiosity. My stay at the prestigious American Carnegie Mellon University was especially rewarding. I specialized in the field of electronics and its use applied to art. After this, I did an internship at the Engine27 gallery in New York City, dedicated to experimental and digital sound.
I decided to continue with my Master’s in Digital Arts at the Pompeu Fabra University in Barcelona.
Years later, I obtained a pre-doctoral fellowship at Harvard University. There I got accepted to attend Professor David Edwards´ innovative course, ¨The Laboratory.¨ This course investigated design-science synergies. I was also at MIT, where I was very lucky to meet Joe Davis, an artist I deeply admire and with whom I shared several fruitful encounters. I also attended classes given by the great artist Antoni Muntadas of MIT Media Lab, thus surrounding myself with a transdisciplinary environment every day.
ZB: You teach Transdisciplinary education as ‘an enhancer of the creation of new knowledge,’ could you please expand more on this idea.
PT: It means we have to dialogue with other professionals from different disciplines about topics of common interest as well as ’empathize’ with them. We must understand the other and embrace other positions as well as approach the languages of different disciplines, their methodologies and processes. Also, it means looking at the problem to be solved or the question to be analyzed from another point of view, outside the mysteriousness of each specialization, to look at the world as if it were for the first time. It means confronting new challenges and experimenting based on previously unimaginable hypotheses.
ZB: IONI (2018) is one of your latest projects developed in a scientific laboratory (this one in particular in a laboratory of microbiology); could you tell us the intellectual process behind it?
PT: This project was created for the group exhibition ‘Narratives in Time and Space´s Fissures,’ and included seven artists, I being the only woman. It took place in the museum at University of Alicante (MUA) during the month of November, 2018 and was curated by Enric Mira, professor and researcher.
I was interested in developing my work in a scientific laboratory and wanted to research concepts of identity, family trace and their ephemeral and temporal characters. I wanted to use vaginal bacteria that represent, in the case of a cis female body, the identity or ID, because of its close relationship with the gut microbiota. According to recent studies, vaginal flora is formed in the intestine and we already know that the gut microbiota is unique in every human being. It is our inner fingerprint.
Space is understood like a time frame as a succession of events and their different narratives, that establish periods with specific characteristics. They produce fissures in the historical-spatial continuity in relation to the human identity’s representation. We are unique beings as well as our microbiota. Unrepeatable. However, we disappear.
I wanted therefore to show this dual character that determines our existence, through the use of bacteria and the images of unique personal events shown in my photographs. I wanted to demonstrate facts that are part of the past, of memory. The vaginal bacteria are integrated within the photographic images (of our history), and installed inside the Petri dishes. With the passing of time, the bacteria (and fungi that proliferate) grow and invade the photographs until they disappear. An ephemeral installation in which only empty contaminated Petri dishes remain and a monitor which produces a video art piece showing my amplified body (through a special lens) and how it is changing. The amplified body image is made with textures and colors as is the painting itself. At the end of the video piece, there is nothing representational about the body, just painting and colors.
ZB: What has been your experience of this artist-scientist collaboration? How do you think bringing artists in the lab can impact science and vice versa?
PT: My experiences outside Spain have always been very positive. I got my first introduction to cross-disciplinary studies at Harvard University and MIT. Then I had a tremendously enriching stay during the Field Notes artistic residency at the Kilpijärvi Biological Station of the University of Helsinki, Finland program created by Ars Bioarctica and the Finnish Bioart Society. But, my collaboration with researchers and students of the Microbiology Institute of the San Francisco University of Quito, Ecuador, was a major part of my impetus to discover more about the synergies between art and science as well as transdisciplinary methodology. I will always be grateful to the whole team for their welcome and professional generosity. It was the first time an artist had entered their laboratory. This created a somewhat complex first period in which we had to achieve closeness and begin to establish ’empathy’ (communication and dialogue). The people were always very kind to me, showing me different scientific techniques as well as the functioning of the laboratory.
In Spain, although I have had relationships with some laboratories and scientific colleagues from the academic scene, there has not been any substantive progress, nor interest in establishing alliances outside of purely academic approaches. That is to say, there have been minimal efforts at collaboration compelled by European funding or some more ¨humble¨ proposals originating from a small research group. I regret that I do not have a more positive ‘picture’ for the near future.
ZB: Where do you see taking your work into?
PT: I am passionate about microbiology, but also genetics, biotechnology, physics, astrobiology It is difficult to choose a specific area of interest. I often go and listen to talks from scientific experts at my university. And I always think about how those discoveries or research could be transformed into ArtScience projects. At the moment I think I Ìll continue working with body bacteria, sound and video.
ZB: What is your chief enemy of creativity?
PT: Routine and Monotony. Absence of passion. Loss of curiosity.
ZB: You couldn’t live without…
PT: Love for life, music, and an inquiring mind.
Interview reprinted with permission from Paz Tornero.
FURTHER LINKS:
NARRATIVAS EN LAS FISURAS DEL TIEMPO Y EL ESPACIO can be viewed at Museo de la Universidad de Alicante,